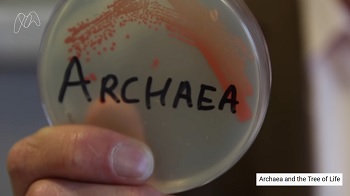
Image of Video

This is a listing of online resources for exploring the Tree of Life, new research, and how fungi fit into the diversity of life.
Videos and sites for Tree of Life
- START HERE. Watch the video: Archaea and the Tree of Life. Shows how the discovery of Archaea changed the tree of life.

- Watch the video: Trying to Make Sense of This Overwhelming World. Using molecular phylogenies to discover relationships. Jul 20, 2020 -- Journey to the Microcosmos.
- Watch the video: The Phylogenetic Tree of Life. Shows the 3 domain tree and adds horizontal gene transfer and endosymbiosis.
- Watch the video: Earth's Entire History. Visualized On A Football Field. Video shows Origin of Fungi with previous estimate of 560 million years ago. Current estimates: between 760 million and 1 billion years ago.
- Teaching the Fungal Tree of Life. David Hibbett lab.

Great sites for explaining phylogenies
- The Tree of Life: Tangled Roots and Sexy Shoots. Tracing the genetic pathway from the Last Universal Common Ancestor to Homo sapiens. By Chris King Dec 2009 - Feb 2020. You can spend hours studying this compilation.
Choanoflagellates: animals closest ancient relative.
- Getting to Know Our Single-Celled Ancestors; Journey to the Microcosmos.

The Cryptomycota papers
- The moldy kingdom gets a new neighbor: Cryptomycota. Andrew David Thaler 2011.
- Jones, M., Forn, I., Gadelha, C. et al. 2011. Discovery of novel intermediate forms redefines the fungal tree of life. Nature 474, 200–203. DOI: 10.1038/nature09984 [PDF]
- Jones, M.D.M., Richards, T.A., Hawksworth, D.L. et al. Validation and justification of the phylum name Cryptomycota phyl. nov. 2011. IMA Fungus 2: 173–175. DOI: 10.5598/imafungus.2011.02.02.08 [PDF]
- Letcher, P.M., and M.J. Powell. 2018. A taxonomic summary and revision of Rozella (Cryptomycota). IMA Fungus volume 9:383–399 DOI: 10.5598/imafungus.2018.09.02.09 [PDF]

New Research on the Tree of Life
- A new view of the tree of life. 2016 Nature. This is a big picture look based on genomes. Bacteria are older and more diverse than Eukaryotes.
- Only two domains, not three: changing views on the tree of life.
Wikipedia and Wikiwand
- Opisthokont on Wikiwand
- Opisthokont on Wikipedia
- Holomycota
- Kingdom Fungi
- Myxogastria
- Chytridiomycota
- Zygomycota
- Glomeromycota
- Ascomycota
- Basidiomycota
- Cryptomycota (Rozellida or Rozellomycota)

See also content here on MycoGuide.com
- Kingdom Fungi
- Introduction
- What are Fungi?
- Phylum Ascomycota
- Phylum Basidiomycota
- Other Fungi, groups of microfungi
For any questions email Patrick Leacock at mycoguide@gmail.com.